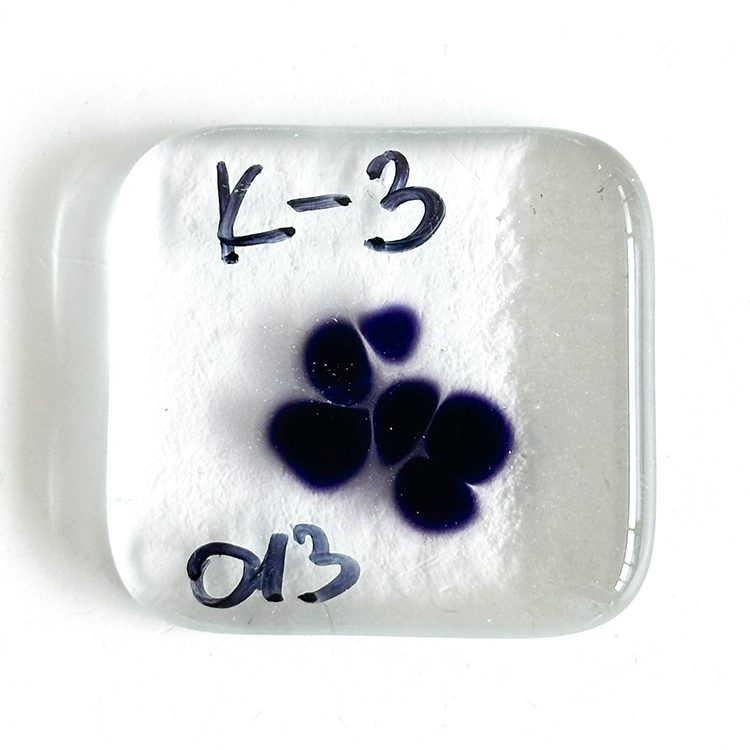

Kugler Frit – K013 – Amethyst Blueish – 96COE
Price range: € 12.50 through € 16.00 Price Excl. TAX
- USD: $ 14.50 - $ 18.56
- GBP: £ 10.88 - £ 13.92
- AUD: $ 22.25 - $ 28.48
- CAD: $ 19.88 - $ 25.44
- JPY: ¥2,150 - ¥2,752
This Amethyst Blueish 96coe can bring vibrant pinks or purples to your 96coe projects
We at Tabitha's Glass Emporium know how hard it is for those using 96coe to get pink and purple colored glass - K013, so we are decided to sell a small range of Amethyst Blueish Kugler Frit to help broaden your glass horizons with these lush colors.
Kugler-Colors® are available in a variety of transparent and opaque colors,. More than 170 different colors are available, including some based on recipes kept strictly secret and passed on for generations.
We have tested each of these colors to make sure they are compatible with Oceanside ice 96coe glass. However please be aware that Oceanside and Kugler are different manufactures, therefor the more you fire them particularly at higher temperatures the more likely you make experience compatibility issues. We therefore suggest doing compatibility tests for your own projects, with the required firing/s before you use them. Tabitha's Glass Emporium takes no responsibility for compatibility issues when using these products.
Product Details
- Available for frits or grits and powder in 100g - slightly less than 4oz bags
- Available for foil / confetti 50g - slightly less than 2oz bags
- In 6 different variety of products
- 4 sized frits, Extra Fine, Fine, Medium and Coarse
- Powder
- Foil
These can be used in:
- Fused Glass
- Lampwork
- Glass Blowing
From experienced professionals to hobbyists, this product caters to all.
The photograph showcases a small fired sample
Due to variations in screen displays, the color may appear different in person than what you see on your specific display.
Only logged in customers who have purchased this product may leave a review.

Reviews
There are no reviews yet.